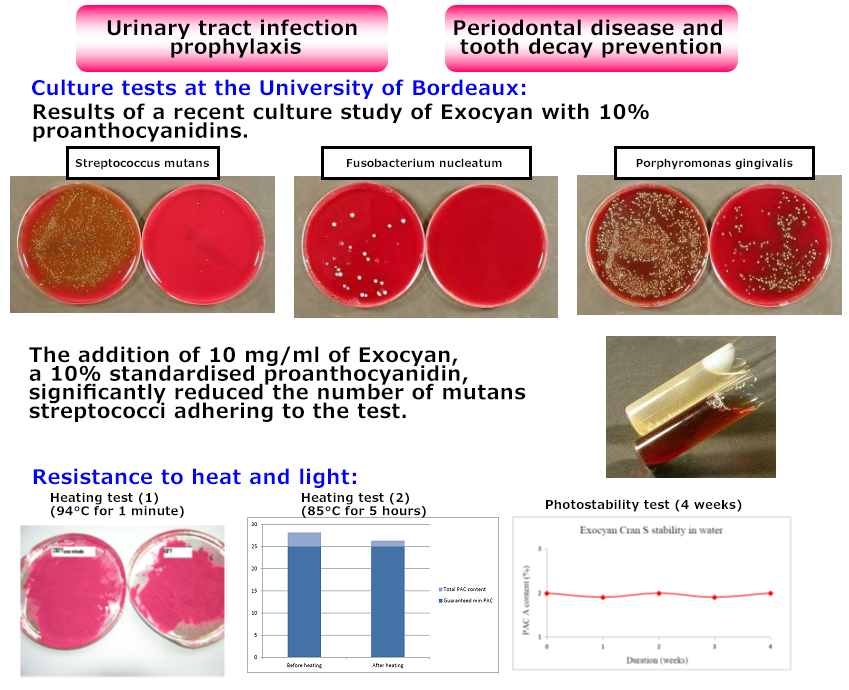

Cranberry Extract Powder
Product Name
Cranberry Extract Powder
Cranberry extract powder containing proanthocyanidins with good antibacterial and antioxidant properties.
A food ingredient with patented uses in urinary tract infection prevention and dental care, used in gums and tablets worldwide.

Features of EXOCYAN

■Cranberry powder containing proanthocyanidins with good antibacterial and antioxidant properties.
■High stability against heat and light.
■Easy to disperse in water and oil.
■Processed and manufactured in France from cranberries grown in North America.
■Has been used in toothpaste, tablets, beverages, gums and supplements all over the world.
Main uses
■Prevention of urinary tract infections and bad breath.
■Anti-ageing and other supplements.
■Confectionery such as chewing gum and candy.
■Urinary tract infection prevention supplements for pets.
■Oral care products for pets.
Lineups
We deal with different grades according to Proanthocyanidin content.
●EXOCYAN S (Contain Proanthocyanidin A 2%)
●EXOCYAN 20S(Contain Proanthocyanidin A 20%)
About the patent of this product
■Patented for urinary tract infections and dental applications.